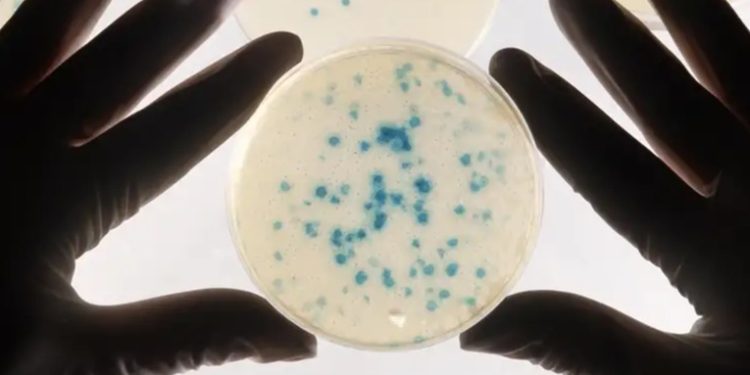
Logran entrenar a bacterias para que detecten cáncer

2023-08-14
Nuevo Mundo – 96.1
En un sorprendente avance científico, un equipo internacional de investigadores ha demostrado cómo los microbios podrían convertirse en aliados cruciales en la detección temprana del cáncer. Aunque pareciera un escenario sacado de una película de ciencia ficción, científicos han logrado entrenar a microorganismos para actuar como detectores de cáncer.Mediante una serie de instrucciones precisas, el equipo de científicos, liderado por el biólogo Robert Cooper de la Universidad de California en San Diego, diseñó bacterias capaces de identificar fragmentos de ADN asociados con células de cáncer colorrectal. Estos microbios modificados, conocidos como «biosensores», podrían marcar un hito en el diagnóstico temprano de esta enfermedad.Acinetobacter baylyi: un aliado en la detecciónLa clave de esta técnica está en el uso de una bacteria llamada Acinetobacter baylyi, que tiene la habilidad natural de recoger fragmentos de ADN de su entorno. Normalmente, esta bacteria utiliza esta capacidad de recolección de ADN, conocida como «competencia natural», para incorporar nuevos fragmentos genéticos a su propio genoma. Sin embargo, en este innovador estudio, los investigadores lograron equipar a A. baylyi con instrucciones específicas para que busque secuencias de ADN asociadas con mutaciones cancerígenas en cánceres colorrectales.Los resultados obtenidos son asombrosos:. A. baylyi demostró ser capaz de discriminar entre mutaciones cancerígenas y errores genéticos inofensivos en el ADN liberado por las células. Cuando la bacteria detectaba ADN tumoral, activaba un gen de resistencia a los antibióticos, lo que permitía su crecimiento en placas de agar con antibióticos, señal de que había detectado células cancerosas. Este enfoque novedoso y prometedor podría ofrecer una manera no invasiva y altamente efectiva de detectar el cáncer de intestino en sus etapas más tempranas.La detección temprana es la claveAunque aún se necesitan años de investigación y ensayos clínicos para validar la eficacia y seguridad de este método en seres humanos, los resultados hasta ahora son alentadores. La científica biomédica Susan Woods, autora del estudio de la Universidad de Adelaida (Australia), comentó, citada por ScienceAlert: «Este estudio demuestra que las bacterias pueden diseñarse para detectar secuencias específicas de ADN con el fin de diagnosticar enfermedades en lugares de difícil acceso».En un próximo paso, el equipo de investigación planea expandir su enfoque para detectar otras mutaciones y tipos de cáncer, lo que podría abrir la puerta a diagnósticos tempranos de diversos tipos de cáncer. La detección temprana sigue siendo uno de los pilares más importantes en la lucha contra esta enfermedad, y la utilización de microbios entrenados como biosensores podría convertirse en una herramienta crucial en esta batalla.
En un sorprendente avance científico, un equipo internacional de investigadores ha demostrado cómo los microbios podrían convertirse en aliados cruciales en la detección temprana del cáncer. Aunque pareciera un escenario sacado de una película de ciencia ficción, científicos han logrado entrenar a microorganismos para actuar como detectores de cáncer.
Mediante una serie de instrucciones precisas, el equipo de científicos, liderado por el biólogo Robert Cooper de la Universidad de California en San Diego, diseñó bacterias capaces de identificar fragmentos de ADN asociados con células de cáncer colorrectal. Estos microbios modificados, conocidos como «biosensores», podrían marcar un hito en el diagnóstico temprano de esta enfermedad.
La clave de esta técnica está en el uso de una bacteria llamada Acinetobacter baylyi, que tiene la habilidad natural de recoger fragmentos de ADN de su entorno. Normalmente, esta bacteria utiliza esta capacidad de recolección de ADN, conocida como «competencia natural», para incorporar nuevos fragmentos genéticos a su propio genoma. Sin embargo, en este innovador estudio, los investigadores lograron equipar a A. baylyi con instrucciones específicas para que busque secuencias de ADN asociadas con mutaciones cancerígenas en cánceres colorrectales.
Los resultados obtenidos son asombrosos:. A. baylyi demostró ser capaz de discriminar entre mutaciones cancerígenas y errores genéticos inofensivos en el ADN liberado por las células. Cuando la bacteria detectaba ADN tumoral, activaba un gen de resistencia a los antibióticos, lo que permitía su crecimiento en placas de agar con antibióticos, señal de que había detectado células cancerosas. Este enfoque novedoso y prometedor podría ofrecer una manera no invasiva y altamente efectiva de detectar el cáncer de intestino en sus etapas más tempranas.
Aunque aún se necesitan años de investigación y ensayos clínicos para validar la eficacia y seguridad de este método en seres humanos, los resultados hasta ahora son alentadores. La científica biomédica Susan Woods, autora del estudio de la Universidad de Adelaida (Australia), comentó, citada por ScienceAlert: «Este estudio demuestra que las bacterias pueden diseñarse para detectar secuencias específicas de ADN con el fin de diagnosticar enfermedades en lugares de difícil acceso».
En un próximo paso, el equipo de investigación planea expandir su enfoque para detectar otras mutaciones y tipos de cáncer, lo que podría abrir la puerta a diagnósticos tempranos de diversos tipos de cáncer. La detección temprana sigue siendo uno de los pilares más importantes en la lucha contra esta enfermedad, y la utilización de microbios entrenados como biosensores podría convertirse en una herramienta crucial en esta batalla.